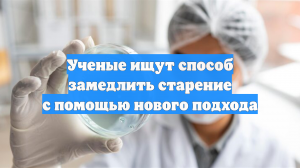
Ученые ищут способ замедлить старение с помощью нового подхода

4:23
4:23
2026-01-29 07:02

 10:52
10:52

 10:52
10:52
2026-01-28 11:10

 4:33
4:33
4:33
4:33
2026-01-29 07:29

 3:54:52
3:54:52

 3:54:52
3:54:52
2026-01-29 07:01

 32:12
32:12

 32:12
32:12
2026-01-28 19:49

 12:25
12:25

 12:25
12:25
2026-01-29 01:00

 2:23:45
2:23:45

 2:23:45
2:23:45
2026-01-25 23:55

 10:25:31
10:25:31

 10:25:31
10:25:31
2025-05-02 07:58

 3:12:39
3:12:39

 3:12:39
3:12:39
2023-09-15 21:20

 11:56:60
11:56:60

 11:56:60
11:56:60
2025-08-29 07:40

 5:36
5:36

 5:36
5:36
2026-01-15 01:44

 2:58:11
2:58:11

 2:58:11
2:58:11
2023-12-21 11:53

 2:32:19
2:32:19

 2:32:19
2:32:19
2023-09-10 18:25

 2:13:04
2:13:04

 2:13:04
2:13:04
2026-01-13 15:24

 3:48:10
3:48:10

 3:48:10
3:48:10
2023-09-18 01:16

 2:27:39
2:27:39

 2:27:39
2:27:39
2025-12-28 21:17

 11:59:14
11:59:14

 11:59:14
11:59:14
2025-12-11 08:06

 1:57:17
1:57:17
![Дана Лахова - Ай, яй, яй (Премьера клипа 2026)]() 2:53
2:53
![Ирина Круг и Вика Ветер - Крестик (Премьера клипа 2026)]() 3:53
3:53
![Сарвар Мадримов - Бора-бора (Премьера клипа 2026)]() 3:09
3:09
![Артур Халатов - Красивая любовь (Премьера клипа 2026)]() 3:23
3:23
![Рустам Батербиев - Стерва-ночь (Премьера клипа 2026)]() 2:24
2:24
![DJ Serzh - Она играла лишь со мной (Премьера клипа 2026)]() 4:12
4:12
![Алишер Файз - Биё-биё (Премьера клипа 2026)]() 3:16
3:16
![Misty - Замело (Премьера клипа 2026)]() 2:44
2:44
![SOPRANO Турецкого & Кай Син - Ах мамочка, на саночках (Премьера клипа 2026)]() 3:40
3:40
![Cvetocek7 - Молния (Премьера клипа 2026)]() 2:41
2:41
![Азамат Пхешхов, Руслан Шанов - Родная (Премьера клипа 2026)]() 3:25
3:25
![Медина Мелик - Дура (Премьера клипа 2026)]() 2:41
2:41
![DJ Serzh - Котолюция (Премьера клипа 2026)]() 3:30
3:30
![Амина Магомедова - Танцуй со мной (Премьера клипа 2026)]() 3:08
3:08
![Артур Бесаев - Там где горы (Премьера клипа 2026)]() 2:15
2:15
![Антон и Альфия - Январская вьюга (Премьера клипа 2026)]() 3:32
3:32
![Шавкат Зулфикор - Жигарлар (Премьера клипа 2026)]() 5:53
5:53
![Dabro - Зима, зима (Премьера клипа 2026)]() 3:17
3:17
![Арина Войт - Смелая (Премьера клипа 2026)]() 2:52
2:52
![Jazzdauren - Юность (Премьера клипа 2026)]() 2:44
2:44
![Протокол выхода | Exit Protocol (2025)]() 1:24:45
1:24:45
![Гарри Поттер и узник Азкабана | Harry Potter and the Prisoner of Azkaban (2004)]() 2:21:46
2:21:46
![Сожалею о тебе | Regretting You (2025)]() 1:55:53
1:55:53
![Игры Биста. 2 сезон, 2 серия | Beast Games 2 season]() 58:23
58:23
![Доверие | Trust (2025)]() 1:30:44
1:30:44
![Отпуск на двоих | People We Meet on Vacation (2026)]() 1:57:55
1:57:55
![Вдохновитель | The Mastermind (2025)]() 1:50:21
1:50:21
![Ловчий смерти | Deathstalker (2025)]() 1:42:60
1:42:60
![Хищник: Планета смерти | Predator: Badlands (2025)]() 1:47:25
1:47:25
![Франкенштейн | Frankenstein (2025)]() 2:32:29
2:32:29
![Пойман с поличным | Caught Stealing (2025)]() 1:46:45
1:46:45
![Игры Биста. 2 сезон, 1 серия | Beast Games 2 season]() 43:55
43:55
![Семейный план 2 | The Family Plan 2 (2025)]() 1:46:14
1:46:14
![Побег из плена | Prisoner of War (2025)]() 1:52:58
1:52:58
![Лакомый кусок | The Rip (2026)]() 1:52:50
1:52:50
![Очень голодные игры | The Starving Games (2013)]() 1:18:55
1:18:55
![Шматрица | Matrix (1999) (Гоблин)]() 2:17:10
2:17:10
![Игры Биста. 2 сезон, 3 серия | Beast Games 2 season]() 57:01
57:01
![Носферату | Nosferatu (2024)]() 2:12:40
2:12:40
![Игры Биста. 2 сезон, 5 серия | Beast Games 2 season]() 49:20
49:20
![Последний книжный магазин]() 11:20
11:20
![Енотки]() 7:08
7:08
![Супер Дино]() 12:41
12:41
![Забавные медвежата]() 13:00
13:00
![Корги по имени Моко. Защитники планеты]() 4:33
4:33
![Школьный автобус Гордон]() 12:34
12:34
![Корги по имени Моко. Домашние животные]() 1:13
1:13
![Ну, погоди! Каникулы]() 7:04
7:04
![Монсики]() 6:30
6:30
![Сборники «Простоквашино»]() 1:05:30
1:05:30
![Отряд А. Игрушки-спасатели]() 13:06
13:06
![Игрушечный полицейский Сезон 1]() 7:19
7:19
![Приключения Пети и Волка]() 11:00
11:00
![Пиратская школа]() 11:06
11:06
![Умка]() 7:11
7:11
![Пингвиненок Пороро]() 7:42
7:42
![Псэмми. Пять детей и волшебство Сезон 1]() 12:17
12:17
![Зомби Дамб]() 5:14
5:14
![Новогодние мультики – Союзмультфильм]() 7:04
7:04
![Сборники «Зебра в клеточку»]() 45:30
45:30

 1:57:17
1:57:17Скачать Видео с Рутуба / RuTube
| 256x144 | ||
| 424x240 | ||
| 640x360 | ||
| 848x480 | ||
| 1280x720 | ||
| 1920x1080 |
 2:53
2:53
2026-01-22 11:17
 3:53
3:53
2026-01-23 18:04
 3:09
3:09
2026-01-14 15:26
 3:23
3:23
2026-01-23 17:57
 2:24
2:24
2026-01-15 13:21
 4:12
4:12
2026-01-12 10:16
 3:16
3:16
2026-01-28 11:55
 2:44
2:44
2026-01-28 12:02
 3:40
3:40
2026-01-20 10:50
 2:41
2:41
2026-01-16 16:41
 3:25
3:25
2026-01-23 19:30
 2:41
2:41
2026-01-13 10:54
 3:30
3:30
2026-01-20 10:30
 3:08
3:08
2026-01-15 13:41
 2:15
2:15
2026-01-16 16:50
 3:32
3:32
2026-01-28 09:47
 5:53
5:53
2026-01-10 14:39
 3:17
3:17
2026-01-23 19:44
 2:52
2:52
2026-01-08 12:25
 2:44
2:44
2026-01-28 11:45
0/0
 1:24:45
1:24:45
2025-11-13 23:26
 2:21:46
2:21:46
2025-12-25 15:40
 1:55:53
1:55:53
2025-12-17 23:52
 58:23
58:23
2026-01-07 23:52
 1:30:44
1:30:44
2025-12-17 23:52
 1:57:55
1:57:55
2026-01-14 15:48
 1:50:21
1:50:21
2025-12-17 00:55
 1:42:60
1:42:60
2025-12-03 17:17
 1:47:25
1:47:25
2025-11-27 03:58
 2:32:29
2:32:29
2025-11-17 11:22
 1:46:45
1:46:45
2026-01-19 12:39
 43:55
43:55
2026-01-07 23:47
 1:46:14
1:46:14
2025-11-26 06:44
 1:52:58
1:52:58
2026-01-26 14:34
 1:52:50
1:52:50
2026-01-23 09:26
 1:18:55
1:18:55
2025-11-21 14:16
 2:17:10
2:17:10
2025-11-17 12:53
 57:01
57:01
2026-01-07 23:55
 2:12:40
2:12:40
2026-01-23 18:44
 49:20
49:20
2026-01-23 13:36
0/0
 11:20
11:20
2025-09-12 10:05
 7:08
7:08
2025-12-30 21:34
 12:41
12:41
2024-11-28 12:54
 13:00
13:00
2024-12-02 13:15
 4:33
4:33
2024-12-17 16:56
 12:34
12:34
2024-12-02 14:42
 1:13
1:13
2024-11-29 14:40
 7:04
7:04
2026-01-12 15:05
 6:30
6:30
2022-03-29 19:16
 1:05:30
1:05:30
2025-06-27 13:20
 13:06
13:06
2024-11-28 16:30
2021-09-22 21:03
 11:00
11:00
2022-04-01 17:59
 11:06
11:06
2022-04-01 15:56
 7:11
7:11
2026-01-20 10:00
 7:42
7:42
2024-12-17 12:21
2021-09-22 22:23
 5:14
5:14
2024-11-28 13:12
 7:04
7:04
2023-07-25 00:09
 45:30
45:30
2025-12-11 18:53
0/0

